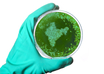

UP has maximum districts with high fertility rate: Health Ministry
IANS | Jul 12, 2017
Over 16 mn fatal lung infections in 2015, India major contributor
IANS | Jul 10, 2017
L-G calls for public sensitization against dengue, chikungunya
IANS | Jul 07, 2017
India's health policy in tune with SDG-3 targets: Nadda
IANS | Jul 07, 2017
India declares itself free from Avian Influenza
IANS | Jul 07, 2017
IIL administers one lakh doses of anti-rabies vaccine
IANS | Jul 07, 2017
Remove wild shrub to cut down malaria cases: Study
IANS | Jul 06, 2017
Medicine capsules not a 'veg vs non-veg' debate, says business chamber
IANS | Jul 05, 2017
NSSO collecting data on communicable diseases for 1st time
IANS | Jul 04, 2017
Himachal doctor dies of swine flu
ANI | Jul 03, 2017
Most read this week